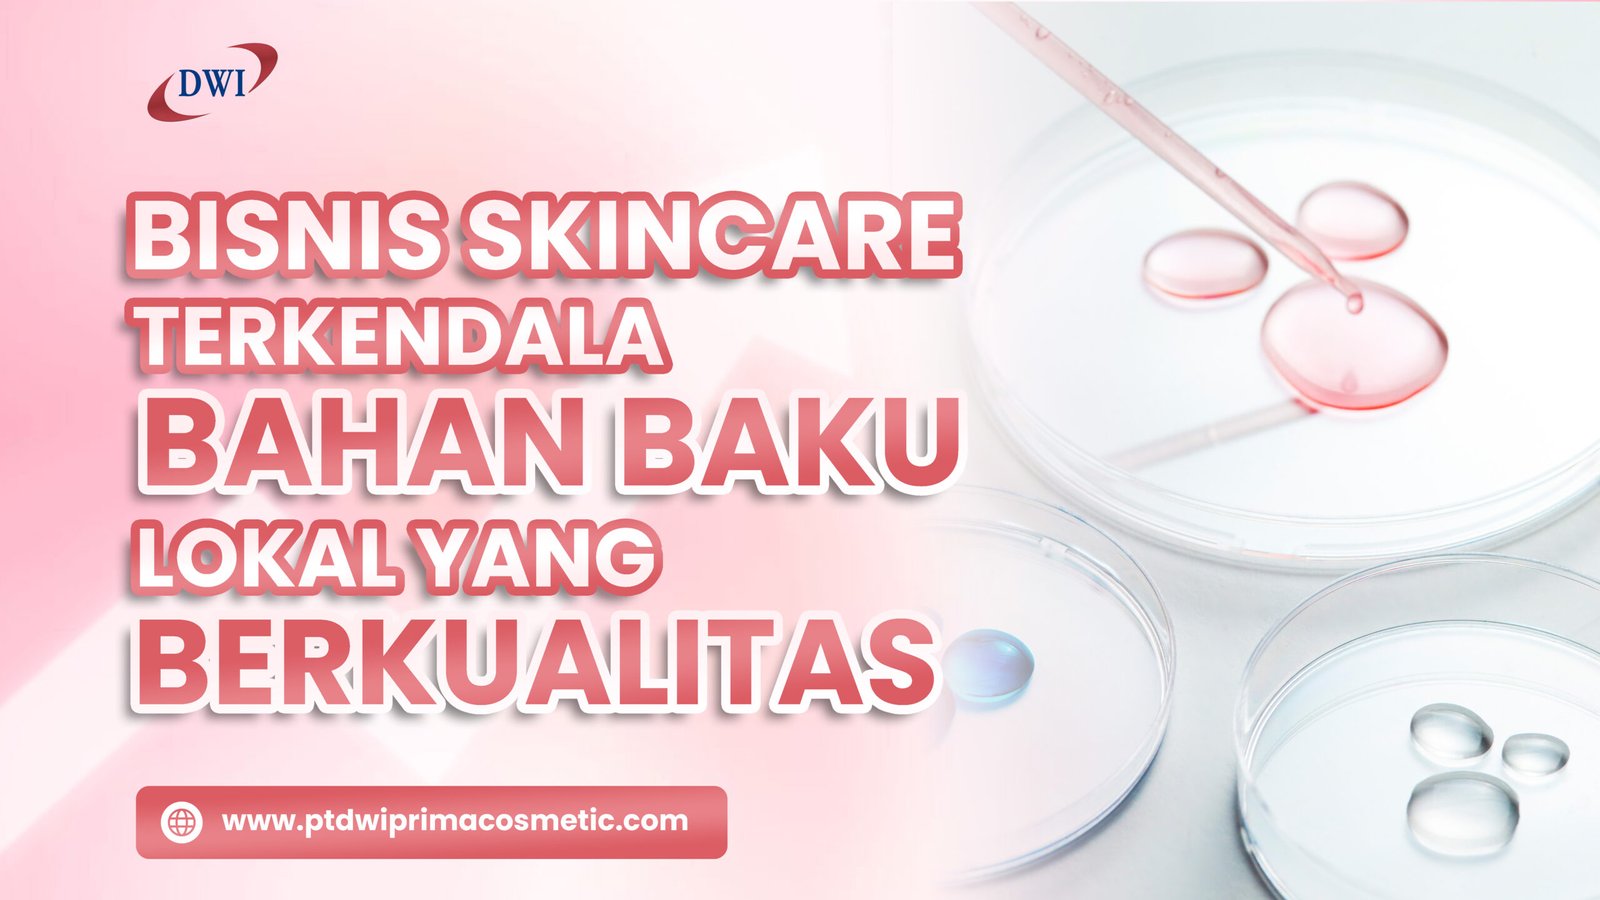
Bisnis Skincare Terkendala Bahan Lokal Berkualitas

![]()
Bisnis Skincare Terkendala Bahan Baku Lokal Yang Berkualitas
Bisnis skincare di Indonesia berkembang sangat cepat, namun banyak pengusaha masih menghadapi tantangan besar: keterbatasan bahan baku lokal berkualitas. Kondisi ini menjadi perhatian serius karena kualitas bahan menentukan keamanan, efektivitas, dan daya saing produk di pasar.
Pentingnya Bahan Baku dalam Industri Skincare
Dalam industri skincare, bahan baku menjadi penentu utama kualitas produk. Konsumen kini tidak hanya melihat tren, tetapi juga memperhatikan keamanan, sertifikasi halal, dan klaim ilmiah.
Jika sebuah brand menggunakan bahan yang tidak memenuhi standar, reputasi mereka bisa rusak. Lebih parah lagi, produk bisa menimbulkan efek samping. Karena itu, setiap pemilik brand harus memastikan bahan yang digunakan benar-benar aman.
Mengapa Bahan Lokal Masih Sulit Dipakai?
Indonesia kaya akan sumber daya alam, tetapi pemanfaatannya di sektor kosmetik masih terbatas. Beberapa hambatan utama meliputi:
- Riset dan pengembangan (R&D) bahan kosmetik yang belum optimal.
- Budidaya dan pengolahan yang tidak konsisten sehingga kualitas sering berubah.
- Fasilitas pengujian yang belum memenuhi standar internasional.
Akibatnya, banyak brand skincare memilih impor bahan dari luar negeri. Padahal, menurut data BPOM, kebutuhan bahan baku kosmetik dalam negeri terus meningkat setiap tahun.
Dampak bagi Brand Skincare Lokal
Ketergantungan pada bahan impor membuat biaya produksi melonjak. Nilai tukar yang fluktuatif juga menambah risiko. Situasi ini memaksa pengusaha mencari strategi baru agar bisa tetap bersaing di pasar yang semakin ketat.
Jika masalah ini tidak segera teratasi, industri kecantikan lokal bisa kehilangan momentum pertumbuhan. Padahal, tren skincare lokal sedang naik daun baik di pasar domestik maupun internasional.
Strategi Mengatasi Tantangan Bahan Baku
Meski kendala masih ada, peluang bisnis skincare tetap terbuka lebar. Beberapa strategi yang bisa ditempuh antara lain:
- Bekerja sama dengan perusahaan maklon skincare yang memiliki akses bahan impor dan formula inovatif.
- Mendukung penelitian bahan alami Indonesia agar bisa bersaing secara global.
- Memanfaatkan teknologi formulasi modern untuk meningkatkan efektivitas bahan lokal.
Dengan langkah ini, brand skincare lokal bisa tetap berkembang sekaligus memperkuat identitas produk buatan Indonesia.
Wujudkan Produk Skincare Impian dengan PT. Dwi Prima Rezeky
Bahan baku lokal berkualitas masih menjadi PR besar dalam bisnis skincare Indonesia. Namun, pengusaha bisa mengatasi tantangan ini dengan inovasi, riset, dan kolaborasi dengan mitra maklon terpercaya.
👉 Jika Anda ingin launching brand skincare tanpa pusing memikirkan bahan baku, PT. Dwi Prima Rezeky siap membantu. Kami menawarkan layanan maklon skincare dengan standar kualitas tinggi, formula inovatif, dan dukungan penuh untuk pengembangan brand skincare kamu.


